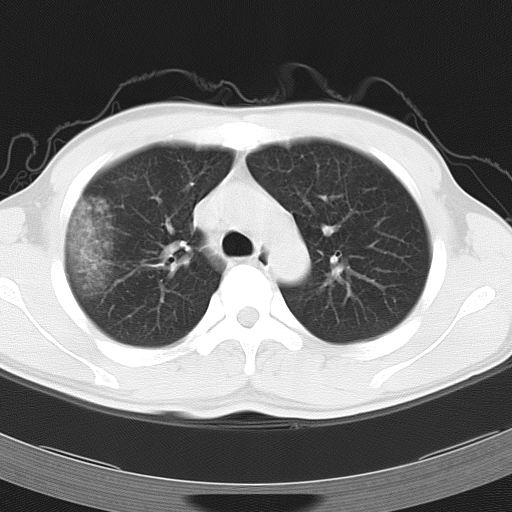
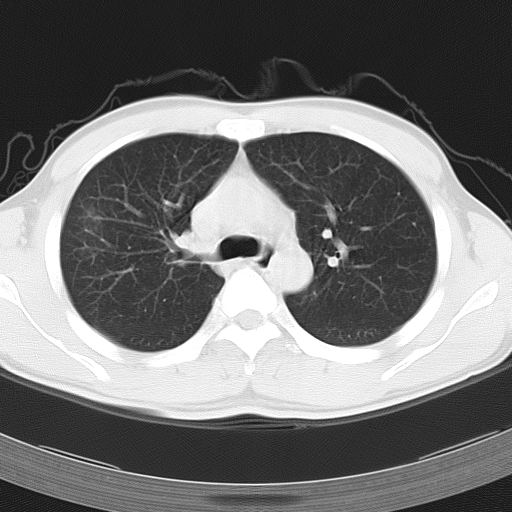
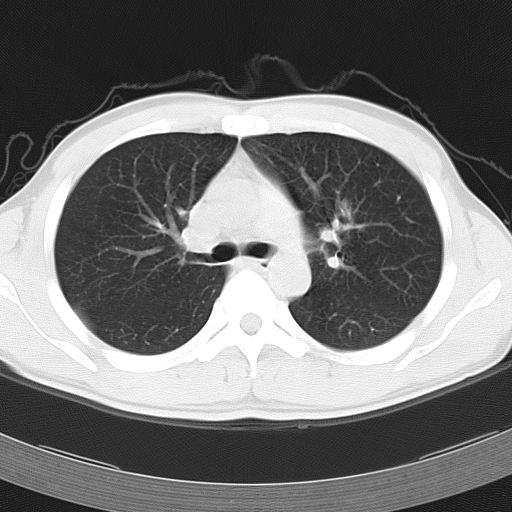
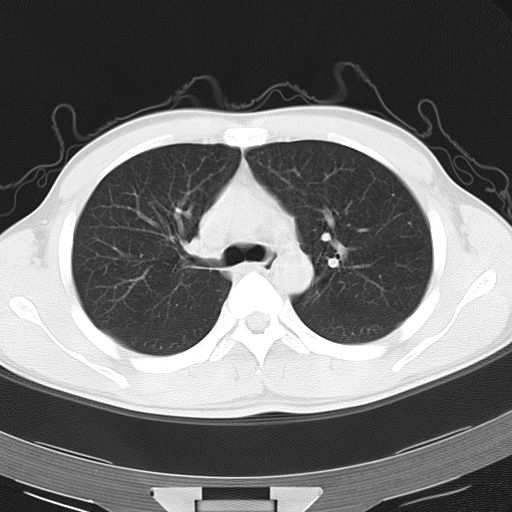

医影在线
标题: CT12379:男,34岁,肺部病变,请求会诊! [打印本页]
作者: yxyxjs 时间: 2008-3-22 19:17
标题: CT12379:男,34岁,肺部病变,请求会诊!
男,34岁,咳嗽2~3个月,无咳血,病初有发热。
请大家分析一下,都能考虑些什么疾病??谢了!













[本贴已被 jiajie 于 2008-3-22 12:29:49 修改过]
作者: 5708 时间: 2008-3-22 19:30
tb
作者: yxyxjs 时间: 2008-3-22 19:35
好象没有那里简单吧?我们想。
作者: 杀毒软件 时间: 2008-3-22 19:58
支持考虑结核可能性大
作者: ZHANGZHONGSHOU 时间: 2008-3-22 20:25
两上肺磨玻璃样改变,均位于肺外周,考虑1、肺泡蛋白沉着症?2、肺泡炎?请询问有无养鸟史 3、脱屑性间质性肺炎?建议进一步检查、复查随访
作者: xiaojianwei 时间: 2008-3-22 20:31
支持考虑结核可能性大
作者: drsjh 时间: 2008-3-22 20:42
两上肺的ggo,靠近胸膜,不是以节段分布,青年男性,个人意见为吸入性的真菌感染可能为大------------呼吸内科医生
作者: zljhyj 时间: 2008-3-22 21:26
过敏性改变?
作者: qiushi 时间: 2008-3-22 21:29
两肺上叶近胸膜磨玻璃样阴影,考虑1、炎性病变。 。2、过敏性炎症?
作者: 形影不离 时间: 2008-3-22 21:47
感染性病变,建议细菌培养及药敏试验。
作者: 鲁巨CT 时间: 2008-3-22 21:57
考虑过敏性肺炎,建议复查,过敏性肺炎最大特点是游走性。
作者: hhcckk 时间: 2008-3-22 22:41
病灶特点:
分布在肺野的外带,病灶边缘清楚,病灶以磨玻璃影为主夹杂少许纤维状高密度影
考虑:
支持zhangzhongshou主任,考虑蛋白沉着症可能性大
蛋白沉着症的影像诊断要点主要包括
(1)斑片状磨玻璃影:指肺野密度朦胧增加,内可见肺血管纹理影,系肺泡腔内充满低密度的磷脂蛋白物质所致。
(2)其内部小叶间隔或小叶内间隔增厚所形成的网格状影,为小叶间隔水肿、肺泡壁内淋巴细胞和巨噬细胞浸润以及小叶内淋巴管扩张的缘故。
(3)病灶边缘清楚,呈地图样分布于肺野外围或肺门及中央区。
需要鉴别的主要有
结缔组织病(如系统性红斑狼疮、风湿等)、特发性间质性纤维化等。
作者: zqguo 时间: 2008-3-22 23:12
两上肺磨玻璃样改变,均位于肺外周,考虑1、肺泡蛋白沉着症?2、肺泡炎?请询问有无养鸟史 3、脱屑性间质性肺炎?建议进一步检查、复查随访
作者: zjzjr 时间: 2008-3-23 01:22
支持肺泡蛋白沉积症可能性大,建议活检.
作者: hanshu 时间: 2008-3-23 01:33
考虑:炎症可能
作者: yangyudong333 时间: 2008-3-23 03:13
考虑肺泡蛋白沉着症
作者: xulianj 时间: 2008-3-23 04:01
肺泡蛋白沉着症可能
作者: zsl6918 时间: 2008-3-23 04:12
病变分布以双上肺叶外带明显,双下肺未见异常,此一点不十分支持肺泡蛋白质沉着症,病变未见铺碎路石征,也不肺泡蛋白质沉着症。考虑间质性肺炎,结核不除外。
作者: 拾荒者 时间: 2008-3-23 05:47
标题: 回复:ct12379:男,34岁,肺部病变,请求会诊!
以下是引用hhcckk在2008-3-22 14:41:00的发言:[br]病灶特点:[br]分布在肺野的外带,病灶边缘清楚,病灶以磨玻璃影为主夹杂少许纤维状高密度影[br]考虑:[br]支持zhangzhongshou主任,考虑蛋白沉着症可能性大[br]蛋白沉着症的影像诊断要点主要包括[br](1)斑片状磨玻璃影:指肺野密度朦胧增加,内可见肺血管纹理影,系肺泡腔内充满低密度的磷脂蛋白物质所致。[br](2)其内部小叶间隔或小叶内间隔增厚所形成的网格状影,为小叶间隔水肿、肺泡壁内淋巴细胞和巨噬细胞浸润以及小叶内淋巴管扩张的缘故。[br](3)病灶边缘清楚,呈地图样分布于肺野外围或肺门及中央区。[br]需要鉴别的主要有[br]结缔组织病(如系统性红斑狼疮、风湿等)、特发性间质性纤维化等。[br]
作者: zcl123658 时间: 2008-3-23 07:38
需排除嗜酸细胞肺炎
作者: zyyzzy 时间: 2008-3-23 07:45
两肺上叶近胸膜磨玻璃样阴影,首先考虑炎性病变(病毒真菌??),不排除肺泡蛋白质沉着症
作者: jinguoji 时间: 2008-3-23 09:24
支持肺泡蛋白沉积症可能性大
作者: 随光逐影 时间: 2008-3-23 16:20
两肺上叶近胸膜磨玻璃样阴影;疑过敏性肺炎。
作者: qc80012345 时间: 2008-3-23 16:32
肺泡蛋白沉积症;胸膜下区磨玻璃样,实变区见纹理走形,地图样改变。做mri。
作者: yxyxjs 时间: 2008-3-23 23:19
标题: 回复:ct12379:男,34岁,肺部病变,请求会诊!
感谢大家的讨论意见!尤其是12楼朋友的精辟分析。根据各位的意见提示,我也参考了一下文献资料,觉得有两条重要依据很符合12楼的诊断。
据报告﹐自7~8个月的婴儿至72岁的老人均有患肺泡蛋白沉积症者﹐但以30~50岁者居多。男性约为女性的3倍。鉴于约半数病人经常接触各种粉尘或有害气体﹐且以硅尘长期给鼠吸入﹐可使动物患肺泡蛋白沉积症﹐故认为本病可能是肺泡对化学性刺激的非特异性反应,导致肺泡巨噬细胞分解,产生pas阳性蛋白质。
该患者男性,34岁,进一步追问病史,该人系矿砂堆场码头工人,长期粉尘环境下工作。--这条病史符合以上特点。
文献报告:x线表现 (1)中央型:肺内弥漫细小模糊结节或羽毛状浸润阴影。其内可见空气支气管征,病变自两肺门向外围延伸分布,形成蝶翼状外貌,甚似肺泡性肺水肿,为本病典型表现。(2)外围型:小叶浸润病变分布于两肺外围或一侧外围,轮廓模糊。
ct表现 (1)中央型:表现为蝶翼状浸润性阴影对称分布于两侧肺门周围,其内可见支气管充气征,病变区与正常肺组织分界清楚。(2)外围型:表现为多发性条片状、斑片状及斑块状高密度影,弥散、对称或不对称分布于两肺或一侧肺外围部位。病变区与正常肺组织及脏层胸膜面分界清晰,呈地图样改变。hrct可显示小叶间隔增厚及肺小叶内淡淡的密度增高影等细微结构,同时易发现肺大疱、肺气囊及节段性肺不张。
再仔细阅读该病人的ct片,我们不难发现,病例所表现的正是外围型的肺泡蛋白沉积症表现,即:为多发性条片状、斑片状及斑块状高密度影,弥散、对称或不对称分布于两肺或一侧肺外围部位。病变区与正常肺组织及脏层胸膜面分界清晰,呈地图样改变。


所以,我本人的意见也是趋向于肺泡蛋白沉积症的诊断,尽管最后诊断还是要根据支气管肺泡灌洗物检查或经纤支镜或剖胸活检作出病理诊断。或痰液检验:咳出的痰经80%乙醇固定,pas染色有15%阳性的脂质。
[本贴已被 yxyxjs 于 2008-3-23 15:28:21 修改过]
作者: panyishengct 时间: 2008-3-24 05:58
过敏性改变?
作者: GEYOQ 时间: 2008-3-24 07:23
支持肺泡蛋白沉积症诊断
作者: zsl6918 时间: 2008-3-24 16:28
请问楼主此病例能追踪观察得到结果吗?病变不一定都按照书本上长,我们不能按图索骥。提几点建议,要么如楼主所言进一步确诊,要么走出去请专家看看,大家都希望能有一个相对准确的结果。希望您有机会把本病例追踪下去。谢谢。如果有说的过重的话,我向您道歉。
作者: yxyxjs 时间: 2008-4-11 05:51
标题: 回复:ct12379:男,34岁,肺部病变,请求会诊!
该病人经过1周抗炎治疗,病灶基本消退,仅存毛玻璃样改变。






作者: yxyxjs 时间: 2008-4-11 05:55
但根据文献记载(http://baike.baidu.com/view/778576.htm),肺泡蛋白沉积症 无特殊治疗﹐60~70%的成人患者可自行恢复。故本人还是觉得该病例自愈的可能性比较大,跟抗炎治疗无直接的关系。
作者: zyx168 时间: 2008-9-19 20:26
肺泡蛋白沉积症
| 欢迎光临 医影在线 (http://bbs.radida.com/bbs/) |
Powered by Discuz! X3.2 |